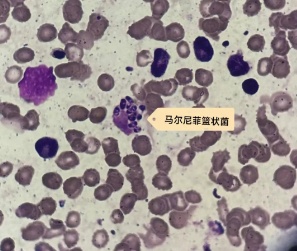
吃竹鼠进补,男子竟惹上"致命"真菌…… 吃竹鼠进补,男子竟惹上"致命"真菌……

40岁的壮哥(化名)
一向身强力壮
前段时间突然高烧到快40℃
浑身疼得像是被揍了一顿
硬扛一周后
他到浙江大学医学院附属第一医院就诊
做CT一查,肺都“烂了”
真凶竟是
一种叫“马尔尼菲篮状菌”的真菌

医院为壮哥做了CT检查,结果显示:双肺弥漫性病灶,血氧饱和度指标不到70%。“重症肺炎,I型呼吸衰竭。再拖下去有生命危险!”他随即被安排住院治疗,并做了基因检测,揪出了真凶——马尔尼菲篮状菌。

▲壮哥的肺部情况
追问之下才知道,身手矫健的壮哥经常到山区竹林里抓竹鼠吃。他觉得竹鼠是滋补好物,吃肉能补身体,冬天来一碗竹鼠汤更是浑身都暖和,却没想到感染了这种素有“致命杀手”之称的真菌。

▲竹鼠(资料画面)
经过抗真菌等一系列治疗后,壮哥已经临床治愈,带药出院回家进行巩固治疗。

马尔尼菲篮状菌,原名“马尔尼菲青霉菌”,是一种生活在自然环境中的真菌,主要分布在东南亚地区和我国南方,竹鼠是它们的天然宿主。当人们吸入含有这种真菌孢子的空气时,就可能发生感染。其一旦钻进人体,会引起致死性深部真菌感染。
这种真菌感染的症状往往很隐蔽,患者多表现为咳嗽、咳痰、胸痛,很容易被当作普通的肺炎或咽喉炎来处理。肺部影像学也缺乏特征性改变,多类似于肺炎、肺结核或肺脓肿病变。
过去,医学界认为这种病主要感染免疫力严重低下的人群,特别是HIV感染患者。此外,老年人、有慢性疾病的患者、长期服用激素等药物的人群也是高风险人群。但壮哥的病例提醒我们,即使是免疫功能正常的人,如果有特定的环境接触史,同样可能“中招”。

预防马尔尼菲篮状菌感染,最重要的是减少高危环境的暴露。
如果必须到竹林等环境中活动,建议佩戴防护口罩,避免直接接触野生动物,注意个人卫生,勤洗手。平时要保持良好的生活习惯,均衡饮食,适量运动,增强自身免疫力。
当出现持续2周以上不愈的咳嗽、咳痰、咽痛,特别是伴有发热、胸痛、气促等症状时,应该立即到正规医院就诊。就医时,一定要详细告诉医生您的症状、发病时间,以及是否有竹林接触史、动物接触史等重要信息。这些看似不起眼的细节,往往是医生诊断的重要线索。
马尔尼菲篮状菌病诊断具有一定难度,但值得庆幸的是,马尔尼菲篮状菌病是完全可以治愈的!治疗的关键在于“三早”:早发现、早诊断、早治疗。
一旦确诊,患者需要在医生指导下规范用药,不能随意停药或减量。大多数患者经过正规治疗后都能获得良好的效果。
综合丨 浙江大学医学院附属第一医院、健康广东
点击右上角
微信好友
朋友圈

点击浏览器下方“
”分享微信好友Safari浏览器请点击“
”按钮

点击右上角
QQ

点击浏览器下方“
”分享QQ好友Safari浏览器请点击“
”按钮
